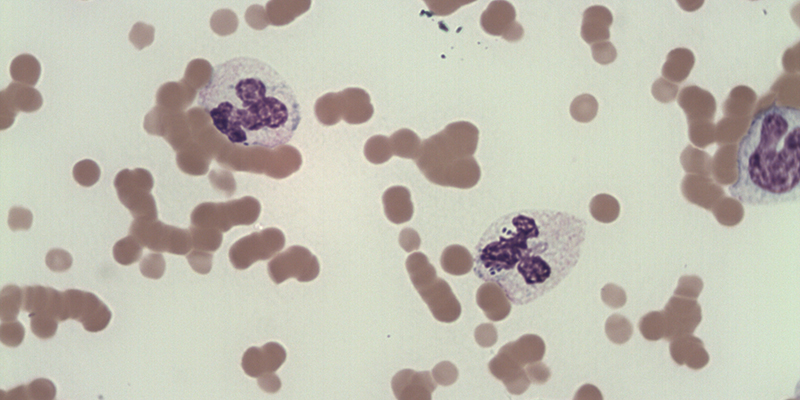

Så arbetar Evidensia med: antibiotikaresistens
Idag blir det mer och mer vanligt att bakterier utvecklar resistens, det vill säga motståndskraft mot antibiotika. Antibiotikaresistensen innebär att de läkemedel som används för att bota infektioner blir verkningslösa.
Mängden antibiotikaresistenta bakteriestammar ökar konstant och utgör ett globalt hot mot folkhälsan och sjukvården. Sveriges resistensläge har hittills varit relativt gynnsamt men även här ökar resistensen.
Bakterier, även de resistenta, kan överföras mellan människor och djur. Därför arbetar Evidensia aktivt mot antibiotikaresistens genom infektionsskydd och infektionskontroll, som en del i vårt ansvar som djursjukvårdaktör. Arbetssättet utgår från ett One Health-perspektiv där samverkan mellan veterinärer och läkare kan hjälpa till att förstå samt motverka smittspridning av kända och nya smittämnen.

Vad beror antibiotikaresistens på?
Bakteriers resistens mot antibiotika riskerar att snabbt förvärras vid felaktig och överflödig antibiotikaanvändning inom både human- och veterinärmedicinen. Därför är det viktigt att antibiotikan nyttjas rationellt – bara när det verkligen behövs och på rätt sätt.
Det mest effektiva skyddet mot bakterier och andra sjukdomsframkallande organismer står inte antibiotika för, utan kroppens egna immunförsvar. En i övrigt frisk kropp läker oftast själv ut en infektion.
Alltför frikostig användning av antibiotika kan rubba balansen i bakteriefloran genom att nyttiga, nödvändiga bakterier slås ut. Detta gör att de motståndskraftiga, i värsta fall sjukdomsalstrande bakterierna, istället gynnas vilket kan leda till ännu värre sjukdomar och till och med döden.
Evidensias arbetssätt för att motverka antibiotikaresistens
När antibiotikans roll som det verksamma vapnet mot infektionssjukdomar håller på att urholkas behöver kampen mot antibiotikaresistens vara en naturlig del på Evidensias djurkliniker och djursjukhus. Vi är noggranna med hygienen så risken för bakteriespridning mellan patienter och från patienter till människor minimeras. Dessutom har vi ett restriktivt förhållningssätt till antibiotikaanvändning.
Arbetet mot antibiotikaresistens grundar sig i:
- Patientsäkerhet – våra patienter är självklart viktigast för oss. Vår huvuduppgift är att göra dem friska och antibiotikaresistens äventyrar detta.
- Arbetsmiljö – våra anställda ska kunna känna sig trygga i att de inte löper ökad risk att smittas med antibiotikaresistenta bakterier genom sitt arbete.
- Arbetsglädje och yrkesstolthet – arbetet mot antibiotikaresistens är ett globalt mycket prioriterat område och det är med stor stolthet vi aktivt medverkar i vårt dagliga arbete.
- Föreskriftskrav – Evidensia följer de krav och föreskrifter som finns inom vården gällande antibiotikaförbrukning.
- Global hållbarhet – vi tar vårt ansvar som djursjukvårdsaktör för en hållbar framtid även ur ett antibiotikaperspektiv.
Riktlinjer för antibiotika inom Evidensia
För konsekvent inställning till och bruk av antibiotika hos samtliga av Evidensias enheter har vår Hygiene Director samt Antibiotic Stewardship Co-ordinator tillsammans tagit fram riktlinjer baserade på antibiotikapolicys från Sveriges Veterinärförbund och de senaste rönen inom antibiotikaområdet. Riktlinjerna är följande:
- Djurets eget immunförsvar är det allra viktigaste verktyget mot infektioner. Antibiotika riskerar att slå ut även nyttiga bakterier och den normala tarmfloran, samt öka risken för utveckling av antibiotikaresistenta bakterier.
- Vi sätter in antibiotika om det inte finns något annat alternativ, till exempel vid livshotande tillstånd, blodförgiftning eller andra allvarliga infektioner. Annars använder vi antibiotika när patientens immunförsvar inte kan förväntas läka ut infektionen.
- Vi ser alltid till bästa möjliga resultat för patienten, men med minsta risk för utveckling av antibiotikaresistens.
- Vi vågar att inte sätta in antibiotika när det inte behövs.
När antibiotika väl används optimeras valet av läkemedel, dos och längd för att förbättra patientens tillfrisknande och minska risken för att utveckla antibiotikaresistens.
Andra alternativa behandlingar till antibiotika:
Evidensia har självklart alltid djurets bästa för ögonen och att lindra ohälsan hos patienten, men det enda sättet att bromsa utvecklingen av antibiotikaresistens i världen är att alla tar ansvar för att använda mindre antibiotika. För att underlätta för djuren att läka ut en infektion utan antibiotika tar vi därför andra alternativa behandlingar och mediciner till hjälp, exempelvis:
- Sår – olika former av sårtvätt och förband som hjälper till att hålla såret rent och binda bakterier.
- Svårläkta hudsår – till exempel antibakteriell gelé och medicinsk honung samt symptomlindrande behandling, exempelvis smärtlindrande medicin.
- Hudinfektion – antibakteriella schampon med till exempel klorhexidin samt symptomlindrande behandling i form av exempelvis klådstillande medicin.
- Mag-tarmstörningar – till exempel anpassat foder, probiotika och andra fodertillkott, samt behandling av kroniska tarmsjukdomar med antiinflammatoriska mediciner.
- Allergiska besvär – olika former av allergimedicin.
Dessa alternativ kan ibland innebära att det tar lite längre tid att läka ut infektionen men är bättre både för det individuella djuret och globala folkhälsan.

Hjälp för infektionskontroll och antibiotikaanvändning
För att medverka och hjälpa till på en nationell nivå ingår Evidensia i både SVASP (Svenska veterinärers nätverk för Antibiotic Stewardship) och Strama vet (Strategigruppen för rationell antibiotikaanvändning och minskad antibiotikaresistens) som båda samverkar kring antibiotikaresistens i Sverige.
Utöver detta har Evidensia egna medel. Evidensias infektionskontrollprogram fungerar som ett slagkraftigt redskap genom utbildning och gemensamma riktlinjer för vårdhygien och antibiotikaanvändning. Evidensia har även ett Antibiotic Stewardship-program vilket innebär en lokal vägledning för veterinärerna på djurklinikerna och djursjukhusen. Detta är unikt för veterinärbranschen och målet är att alla Evidensias kliniker ska inkluderas i programmet för att ytterligare förbättra arbetet mot antibiotikaresistens.
Slutligen, tack vare ett gemensamt journalsystem inom Evidensia kan vi också övervaka den antibiotika som används och förskrivs i samband med våra drygt 500 000 patientbesök årligen.
Framtiden för den moderna veterinärmedicinen handlar om att förhindra antibiotikaresistensens framfart. Genom utveckling kan vi fortsätta göra det som är viktigast för oss, att hjälpa patienterna.